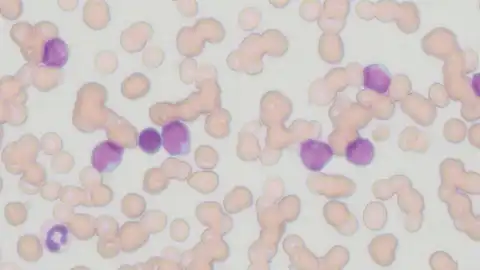
With high-powered objective
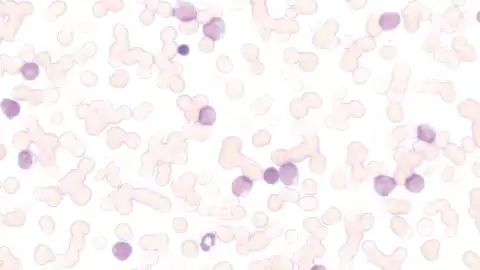
With low-powered objective
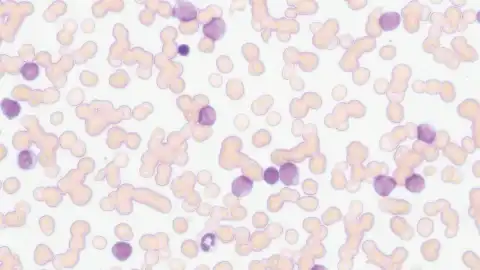
With low-powered objective
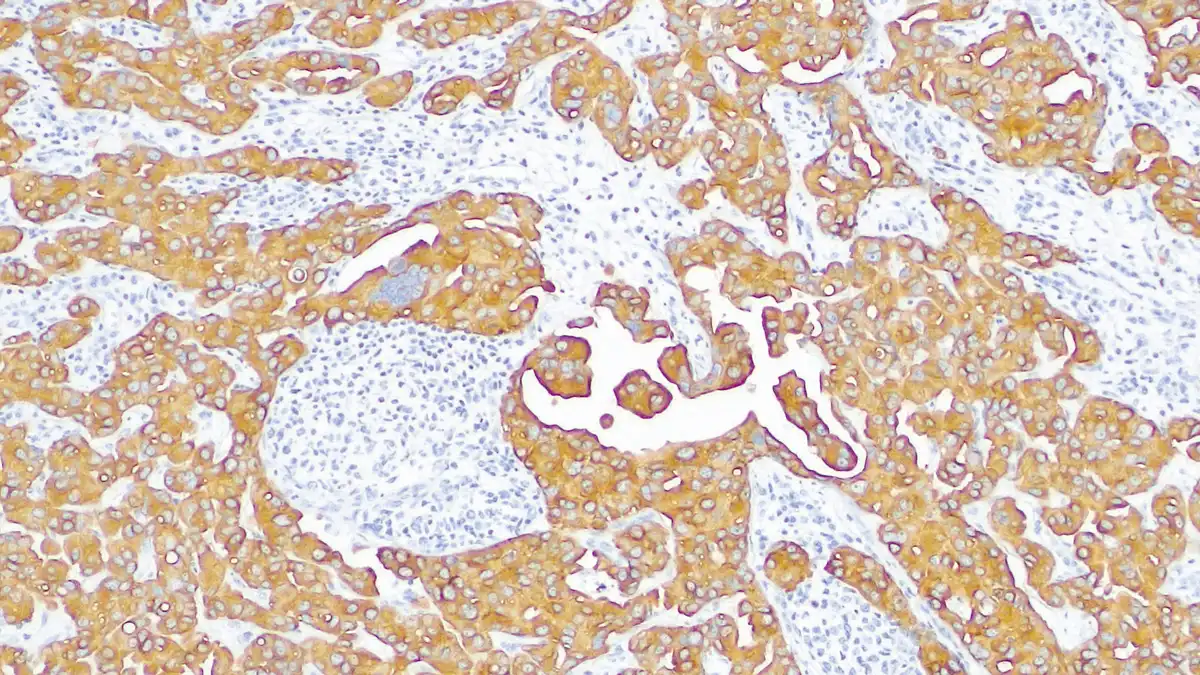

NIKON ECLIPSE Si
Biological microscope
Focus in comfort. Comfort in focus.
Nikon has designed the ECLIPSE Si to meet the rigorous demands of professionals who spend hours using the microscope. The ECLIPSE Si is ergonomically designed to enhance operational efficiency. This powerful instrument helps you to stay focused for longer by reducing the strain on your body. The ECLIPSE Si is the new standard in microscopes, expanding the possibilities of exploring the micro world.

Key Features
Pursuing efficient workflow
The ECLIPSE Si has been developed with the primary goal of reducing fatigue during microscope usage. The ECLIPSE Si eliminates unnecessary adjustments and enables efficient and comfortable operation. The ergonomic design also enables natural posture, even when carrying out repetitive tasks.

Maintaining comfortable brightness when switching magnifications
Objectives with different magnifications transmit light to varying degrees. Therefore, light intensity must be adjusted every time the user changes the objective. In addition, when switching from high to low magnification objectives, the sudden increase in brightness often causes eye strain. The ECLIPSE Si features the intelligent Light Intensity Management (LIM) which automatically remembers and sets the light intensity level for each objective. The LIM feature reduces up to 40% of the time spent on adjusting light intensities*. With the ECLIPSE Si, users can increase comfort and save time even when the routine requires frequent magnification changes.
* Compared to the time required for adjusting the light intensity when switching among three different objective lenses. Test was carried out by Nikon, using a previous LED-based microscope model.

Briefly press the light intensity control knob to activate the LIM function
LIM feature OFF
Since brightness varies depending on the objective, switching magnifications can induce eye strain.


With high-powered objective With low-powered objective
LIM feature ON
The optimal light intensity level is automatically recalled and applied to each objective, therefore eliminating unexpected changes in light intensity when changing magnifications and streamlining workflow.


With high-powered objective With low-powered objective
Low stage for effortless slide replacement
The height of ECLIPSE Si stage is 135 mm, which is about 50 mm lower than our conventional microscopes. The lower stage design reduces the range of motion required to exchange specimen slides, and in turn this can reduce arm and shoulder fatigue. Since the position of the stage movement knob is also lower, different areas on the specimen slide can be easily explored while resting your hands on the table. The lever for opening and closing the specimen holder has also been designed to be ergonomic with an easy-to-operate size and shape. Furthermore, the ECLIPSE Si features a 30% smaller stage compared to our conventional microscopes in order to optimise slide replacement.


Conventional microscope ECLIPSE Si Easy-to-operate specimen holder
Enables natural posture to be maintained throughout the entire microscope workflow
The inclination angle of the eyepiece tube is 45 degrees, which enables observation through the eyepieces while maintaining a natural posture. The low stage design also allows you to seamlessly switch from looking through the eyepieces to checking the slide placement on the stage without having to adjust your posture. An optional eye-level riser is also available to further tailor the height of the eyepieces.


Eye-level riser Check on the stage while maintaining the observation posture
Worry free focusing thanks to vertical stop
The ECLIPSE Si is equipped with a stopper that can be used to set the upper limit of the stage height. The stage stops at the set height even when the focus knob is turned, thereby eliminating the risk of over-focusing and breaking the slides or damaging the objectives. Specimen exchange and focusing can be performed with confidence, without worrying about the stage height.


Easy operation just by turning the screw at the height you want to set The stage does not rise above the set height.
Pursuing stress-free ease of use
We wanted to design a microscope that would eliminate fatigue incurred by frequent specimen exchanges and provide a more comfortable user experience. The ECLIPSE Si combines innovative features and intelligent design to minimize unnecessary body movements, saving time and reducing strain on the user even when examining a large number of slides.
Adjusting focus and moving the stage with one hand
The coarse and fine focus knobs are located on both sides of the microscope, making it possible to focus with either hand. In addition, the stage handle is positioned close to the focus knob, allowing users to easily adjust both the stage position and focus with the same hand. With the stage movement and focus controlled by the same hand, the other hand can be dedicated to rotating the nosepiece or replacing the slides. These features provide an efficient workflow even when examining a large number of specimen slides.


Coarse focus knob Fine focus knob Coarse/fine focus and stage movement can be operated with one hand
Status display
The illumination brightness is shown in a bar graph on the LCD. You can check the magnification at a glance while maintaining your observation posture.
❶ECO mode: ON ❷LIM function: ON ❸Objective name ❹Magnification ❺Brightness state

Knob rotation direction display
The direction of rotation of the focus and brightness control knobs can be intuitively grasped.

No hesitation in choosing a knob to operate
The icon of the stage movement knob to be operated is illustrated on the travel scale of the specimen in the forward-backward and right-left directions.

Changing magnifications comfortably
The reversed-type nosepiece provides easy access and visibility to the objective in use. The position of the nosepiece is low to reduce strain on the arm when frequent magnification changes are required. The nosepiece features an easy grip for smooth rotation, and accommodates up to five objectives to provide a wide range of magnifications.

Easy-to-rotate quintuple nosepiece
Blocks blue component in LED light
Since LED light contains a large amount of blue or short wavelength light, there is concern that prolonged observation may put a strain on the eyes. The ECLIPSE Si offers an optional blue light blocking filter that can be placed on the field lens to remove the blue component of the LED light.

Automatically turning off illumination after a certain period of time
The ECLIPSE Si is equipped with an ECO mode which automatically turns off the illumination after a certain period of inactivity. The length of the inactivity period is adjustable. With ECO mode, the ECLIPSE Si helps you save power without any effort.

Press and hold the brightness control knob to turn on the ECO mode.
Easily share images on-site and remotely
Capture specimen images for documentation or for real-time sharing with others by configuring the ECLIPSE Si (trinocular version) with a digital camera.
When the ECLIPSE Si is configured with the Digital Sight 1000 microscope camera (optional), images of specimens can be easily displayed on the monitor for simultaneous observation by multiple people, and recorded without the use of a PC. Furthermore, by connecting the camera to a tablet PC*, images can be shared in real time with remote or off-site PCs and smart devices via a network. The DS-Fi3* high-definition microscope camera, which faithfully captures the true colors of specimens, is also available.
* NIS-Elements L imaging software is required.


Simultaneous observation and display of specimens on a monitor Share images in real-time with PCs in another room or building
Superior Optics for High Quality Images
Nikon’s advanced optical technologies, culminating from a long tradition as a microscope manufacturer, play a vital role in the ECLIPSE Si. The ability to fulfill the need for accurate observation of specimens is a source of pride for us.
Excellent image flatness and chromatic aberration correction
The ECLIPSE Si employs CFI E Plan series objectives, which feature flat, sharp images up to the periphery of the field of view. These objectives are part of the CFI60 infinity-corrected optical system, which achieves both high resolution and long working distances. A wide variety of Nikon CFI60 objectives are available.

CFI E Plan series objectives
Observation with FOV of 22mm
The ECLIPSE Si can enhance the efficiency of clinical observations when equipped with FOV22 tubes* and lenses that enable a large 22mm field of view.
*C-TB, C-TF, C-TT and C-TE2 tubes

Long-life LED with constant color temperature
The high-intensity, white LED light source, features a long life of up to 60,000 hours. Since the color temperature remains constant even when the brightness is changed, the color of the image does not change when changing magnifications.


Uniform brightness up to the periphery of the field of view
The illumination system features an integrated fly-eye lens which provides uniform brightness over the entire field of view.

Fly-eye lens
Blocking light from outside the field of view
The ECLIPSE Si is equipped with a field diaphragm that can be used to limit the illumination range for optimal observation and image acquisition. Adjusting the field diaphragm suppresses the occurrence of flare and ghosting, enabling high contrast image observation. During fluorescence observation, the range of photobleaching of specimens can also be limited.

Turn the field diaphragm dial until the illumination range is circumscribed to the field of view.
Compatible with a Wide Variety of Observation Methods
Using optional accessories, the ECLIPSE Si allows for a wide variety of observation methods in addition to brightfield.
Brightfield observation
High-quality images can be acquired with bright, uniform illumination over the entire field of view, using objectives with superior image flatness and excellent chromatic aberration correction.

Phase contrast observation
Combining of a phase condenser and phase contrast objectives enables observation of colorless and transparent specimens with high contrast, without staining or labeling the specimens with dyes. A standard Abbe condenser, with a PH slider inserted, also allows phase contrast observation.


Hardware required for phase contrast observation:
❶ CFI DL phase contrast objectives, ❷ GIF filter, ❸ Centering telescope
And either:
❹ Phase contrast sliders (set of 2) or ❺ Phase Condenser with Condenser height adjustment tool
Darkfield observation
By inserting a slider for darkfield microscopy into the condenser slot and using oblique illumination, light scattered by specimens can be visualized. This method is effective for observation of unstained specimens such as live bacteria and examination of colloidal particles.
The CFI E Plan Achromat 4X objective is not suitable for darkfield observation.


Slider for darkfield microscopy
Simple polarizing observation
By attaching a polarizer to the field lens and an analyzer to the eyepiece tube mount, simple polarizing observation can be performed. The polarization state can be adjusted by turning the polarizer.


Polarizer and analyzer for simple polarizing
Diascopic fluorescence observation
Nikon has developed a unique diascopic fluorescence illumination method that enables easy fluorescence observation without attaching dedicated episcopic illuminator and fluorescence observation equipment. By simply inserting an EX filter slider into the condenser slot and a BA filter slider into the nosepiece slot, fluorescence observation of specimens expressing GFP or stained with fluorescent dyes such as FITC and Alexa 488 can be performed.


Diascopic fluorescence set
Online Guide accessible with a Smartphone
You can access a web-based operation manual for the ECLIPSE Si on your smartphone by simply scanning the QR code* sticker attached to the microscope. The Online Guide provides visual instructions including movies that enable you to quickly check how to setup and use the microscope. To access the Online Guide directly, click here.
* QR code is a registered trademark of DENSO WAVE INCORPORATED.


Emphasis on easy storage
The ECLIPSE Si also focuses on easy storage after observation. It features a lightweight, easy-to-carry design, and the power cord can also be conveniently housed.
Easy to Carry
The body of the ECLIPSE Si is 14% lighter than that of the previous model*. Grips on both sides of the microscope base and rear arms make it easy and stable to carry. In addition, the eyepieces can be securely fixed with screws to prevent them from falling during transportation.
* An LED model
Easy storage
The tube can be rotated backwards to reduce the space required for storage by loosening the tube locking screw. The tube is designed so that it does not fall even if the screw is loosened. The direction of rotation is clearly illustrated on the body.
Moreover, the AC adaptor can be stored at the back of the microscope, and the power cord can also be neatly wound up when storing.



Optional accessories
Digital Sight 1000 microscope camera
Equipped with a 2-megapixel CMOS image sensor, the Digital Sight 1000 can acquire color images and movies of up to 1920 x 1080 pixels. Just connect a monitor* and a mouse, and you can easily capture images without using a PC.
* Via a HDMI cable.


Simple measurements including distances between two points and areas are possible.
DS-Fi3 microscope camera
Equipped with a 5.9-megapixel CMOS image sensor, the DS-Fi3 can acquire high-resolution color images of up to 2880 x 2048 pixels*. Its excellent color reproducibility enables the acquisition of images with colors faithful to those of the images observed under the microscope. Its high sensitivity also makes the DS-Fi3 ideal for acquiring fluorescence images.
* NIS-Elements L imaging software is required for controlling the camera.

NIS-Elements L imaging software
By connecting the Digital Sight 1000 or DS-Fi3 to a tablet PC with NIS-Elements L installed, images of specimens under observation can be shared with other PCs via a network. The software also contains a variety of measurement and annotation functions.

Teaching Head
Enables simultaneous observation by two people using the same microscope. Available in two types: face-to-face type and side-by-side. Areas of interest can be indicated with the built-in LED pointer.

Face-to-face type Side-by-side type
Eye-level Riser
By mounting the eye-level riser under the eyepiece tube, the eyepoint can be raised by 25 mm. The height of the eyepiece can be adjusted to fit the observer, which allows observation in a comfortable posture.

Up to two pieces (50 mm) can be mounted.
Digital Sight 1000, DS-Fi3 microscope camera, and NIS-Elements L Imaging software are not for medical purposes.
Cooperation between pathological specimens and imaging guidance Dr. Yasushi Nakamura, Pathologist, Osaka Cytopathological Laboratory
 ECLIPSE Si_Brochure_EN
ECLIPSE Si_Brochure_EN



 Microsystem
Microsystem Endoscopysystem
Endoscopysystem Energysystem
Energysystem EndoscopyConsumables
EndoscopyConsumables +86-21-54286005
+86-21-54286005 
 Room 602, Building 1, No. 111 Luxiang Road (Greenland Park Plaza), Baoshan District, Shanghai, China
Room 602, Building 1, No. 111 Luxiang Road (Greenland Park Plaza), Baoshan District, Shanghai, China  English
English
 中文
中文

中文
中文 English
English